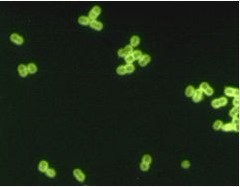

脊髓液中的肺炎链球菌经FA染色剂染色后的数码彩色图片,图片来自维基共享资源。
遗传学在解释为什么在英国和美国使用的对抗儿童严重性细菌感染的疫苗部分失效的原因方面起着很重要的作用。根据2012年1月29日发表在《自然-遗传学》上的一篇新研究论文,科学家研究了细菌如何改变伪装逃避疫苗检测,从而对未来如何能够设计出更加有效的疫苗产生深刻影响。
肺炎链球菌(pneumococcus,拉丁学名Streptococcus pneumoniae)导致潜在性的危害生命的疾病,包括肺炎和脑膜炎。尽管在英国和美国之类的国家疫苗项目的成功开发导致肺炎链球菌感染病例数量显著性下降,但是在全世界每年肺炎链球菌感染被认为杀死大约一百万幼儿。这些疫苗通过在肺炎链球菌细胞外面发现的多糖识别这种细菌。共有90多种不同种类或者说血清型的肺炎链球菌,其中每种有着不同的多糖包被。
2000年,美国引入一种识别90种血清型肺炎链球菌中7种的疫苗。这种“七价(7-valent)”疫苗是非常有效的,而且在它作用的年龄组中显著性地降低感染疾病。引人注目的是,这种疫苗也阻止幼儿把肺炎链球菌传染给成人,从而导致每年减少成千上万例肺炎链球菌感染疾病。2006年,这种相同的疫苗也被引入英国而且获得类似的成功。
尽管这些疫苗项目大获成功,但是一些肺炎链球菌菌株通过伪装它们自己逃避疫苗作用成功地继续导致疾病发生。在接受英国维康基金会(Wellcome Trust)资助的研究中,来自英国牛津大学和美国疾病控制与预防中心的科学家研究了这种疫苗引入美国后发生的事情。他们使用最新的基因组技术同时结合流行病学方法以便理解不同血清型肺炎链球菌如何进化从而替换初始时能被疫苗识别的肺炎链球菌菌株。
研究人员发现肺炎链球菌通过将基因组中负责制造多糖包被的DNA区域与疫苗不能识别的不同血清型肺炎链球菌的相同DNA区域发生交换从而逃避疫苗作用。这有效地让细菌发生伪装,使得它对疫苗隐形。这种基因组区域交换在重组过程期间发生,即一种细菌用来自另一种细菌类型的DNA片段替换它自己的DNA片段。
牛津大学Rory Bowden博士解释道,“想象一下每种肺炎链球菌菌株是一班都穿着校服的小学生。如果一个男孩在警察开设的街角小店里偷窃,警察---在这种情形是疫苗---通过看一下他的校服能够很容易鉴定出他来自哪所学校。但是如果这个男孩跟来自另一所学校的朋友交换校服,警察将不再识别他,因而他能够逃脱。这就是肺炎链球菌逃脱疫苗检测的方法。”
Bowden博士和同事鉴定出成功地逃避疫苗检测的许多发生重组的血清型肺炎链球菌。特别是其中一种肺炎链球菌经常生长,在几年内从美国东部传播到西部。他们也证实在重组期间,这种细菌同时也交换基因组中许多其他部分,而这种现象之前从没有在自然的肺炎链球菌群体中观察到。因为涉及多种DNA片段的重组允许细菌基因组的关键区域同时发生交换,从而潜在地允许它快速地产生抗生素抗性。
如今,在美国这种原始七价疫苗已被13价疫苗所替换。这种13价疫苗识别13种血清型,其中就包括逃避这种原始七价疫苗识别的特定血清类型。在英国,该七价疫苗总体上导致疾病显著下降。这种总体效应是该疫苗识别的血清型肺炎链球菌感染病例数量大幅下降,同时该疫苗不能识别的血清型感染病例数量表现出一定的增加。2010年,这种13价疫苗也被引入英国。
牛津大学微生物学教授Derrick Crook也是牛津大学医院国家卫生服务信托的感染控制医生。他补充道,“在我们容易遭受严重性感染的阶段,儿童疫苗非常有效地降低疾病和死亡。理解是什么导致疫苗有效和是什么能够导致它失效是非常重要的。如今我们应当能够更好理解当一种肺炎链球菌疫苗引入到新人群时会发生什么。我们的研究提示着当前开发新疫苗的策略是很有效的,但是可能并不像人们希望中那样长期有效。”
美国疾病控制与预防中心科学家Bernard Beall博士评论道,“当前识别占优势地位的肺炎链球菌血清型的疫苗策略是极其有效的,然而我们的研究结果表明这种细菌将继续适应这种疫苗开发策略并且将成功地进化出一些人们可以检测到的逃避疫苗作用的菌株。”
部分资助这一研究的维康基金会将对抗传染病和最大化遗传研究的健康益处作为两种优先策略。维康基金会分子和生理科学部门主任Michael Dunn博士评论道,“新技术允许我们快速地对导致疾病的有机体进行测序和观察它们如何进化。通过与流行病学家合作,我们能够追踪它们如何扩散和监控这将对疫苗疗效带来的潜在性影响。这将为疫苗执行策略提供有用的启示。” (生物谷:towersimper编译)
新闻来源:http://www.bioon.com/biology/Immunology/516440.shtml

留言